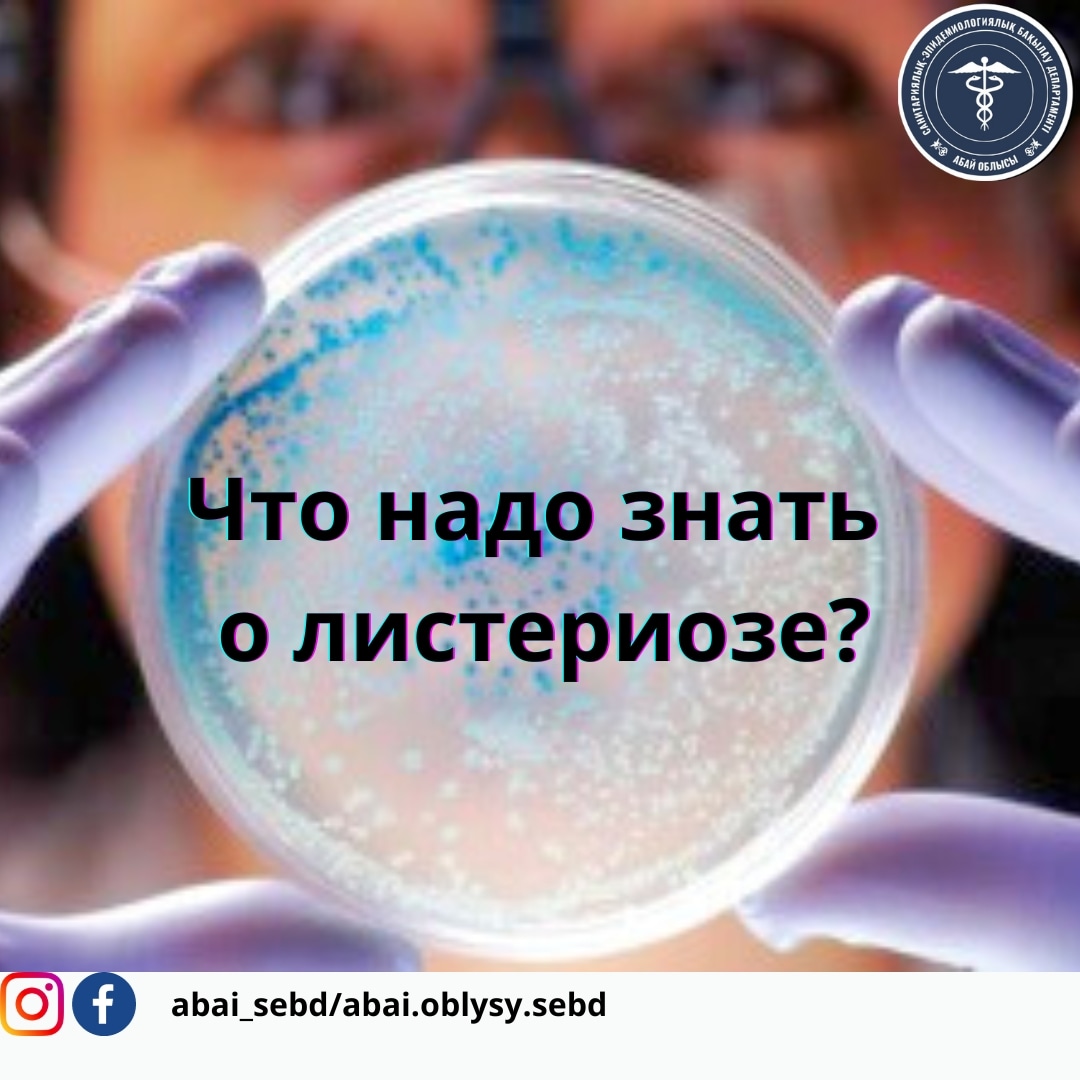
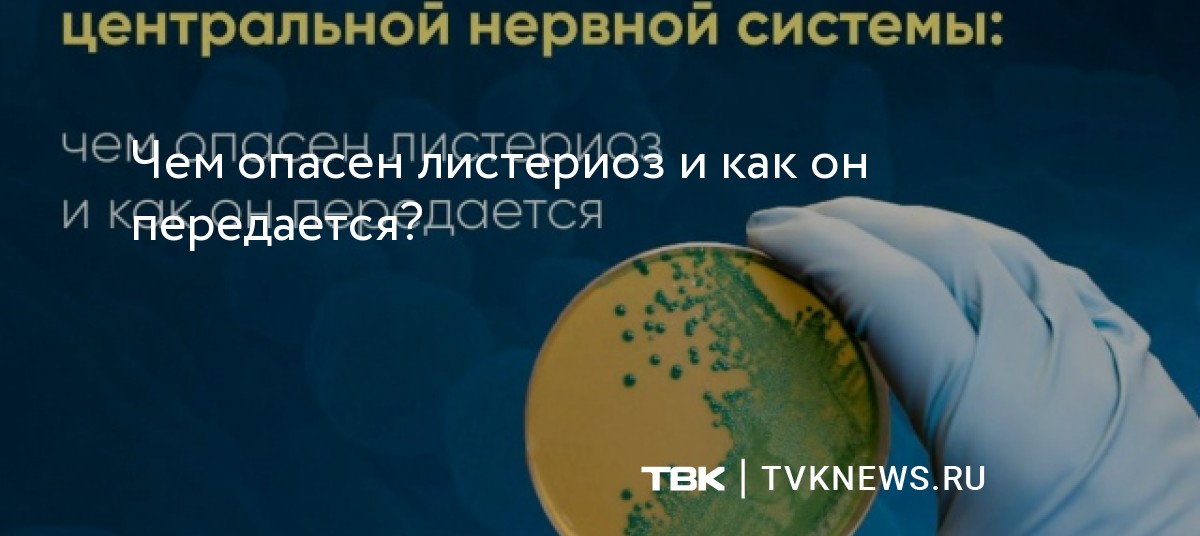

Листериоз пути заражения
Листериоз пути заражения 109 фотографий
Сайт школы 1 псков
Поэтапное рисование простыми карандашами
Контур экстерн малый
Шляпочные грибы обитание
Французский язык за 16 часов урок
Белгородский институт кооперации экономики
Half billion
Монарда как сажать
Канавинский автовокзал телефоны
Температура при гашении извести
Чем опасна черепно мозговая
Часы samsung galaxy watch active2
Кухня кинь
Экран для стола с креплением
Открытый город чебоксары голосование
Картинка со сказочными героями
Что нужно указать чтобы функция считалась заданной
Американский боевой танк
Что значит объект в проекте
Развитие инфраструктуры школы